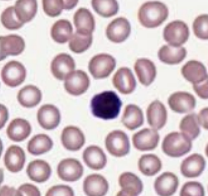
<p>what iam </p>
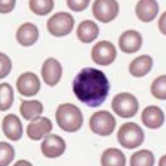
<p>what iam</p>
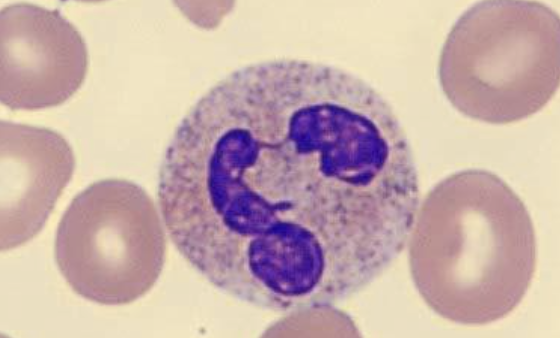
<p>what iam</p>
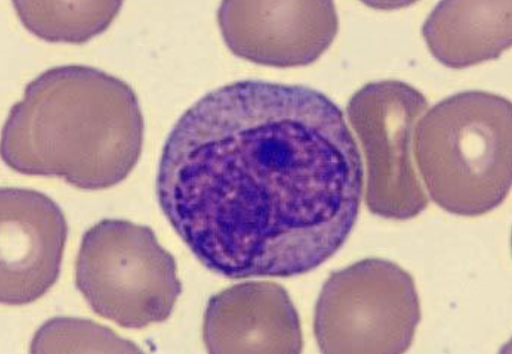
term image
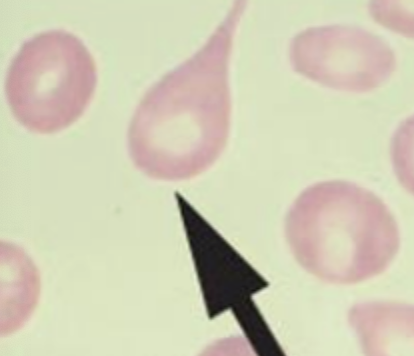
<p>dacrocytes or teardrop cells</p>
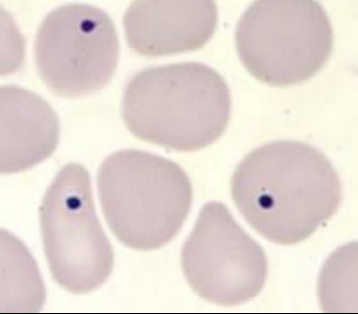
term image
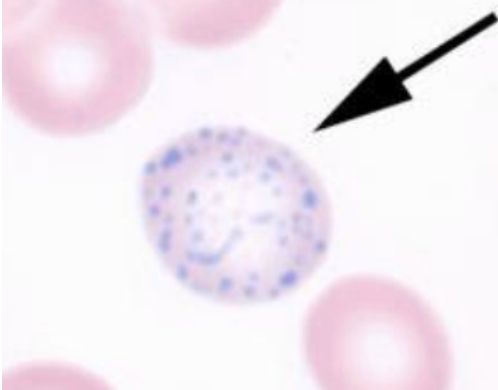
term image
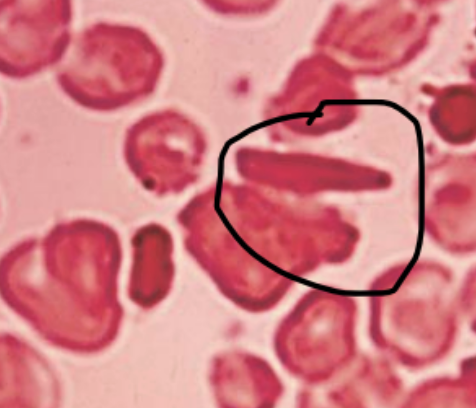
term image
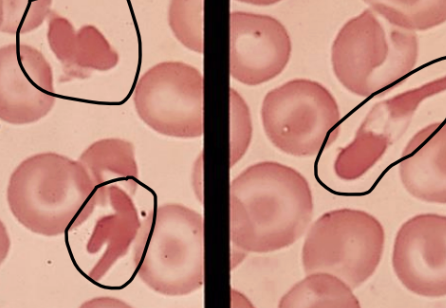
term image
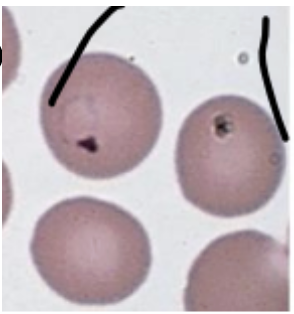
term image
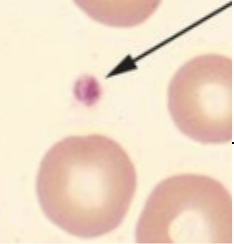
term image
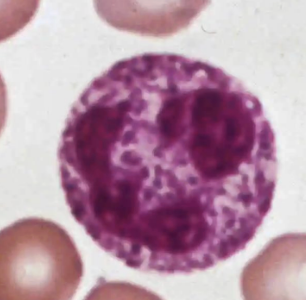
term image
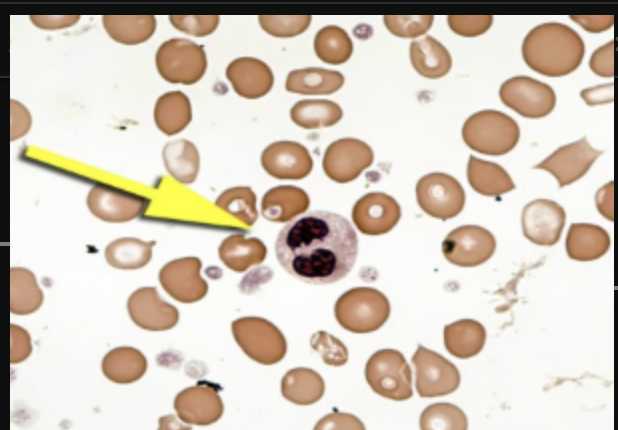
term image
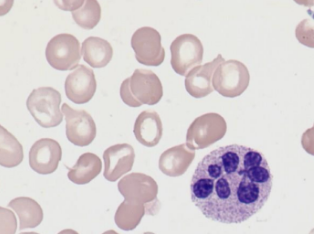
term image
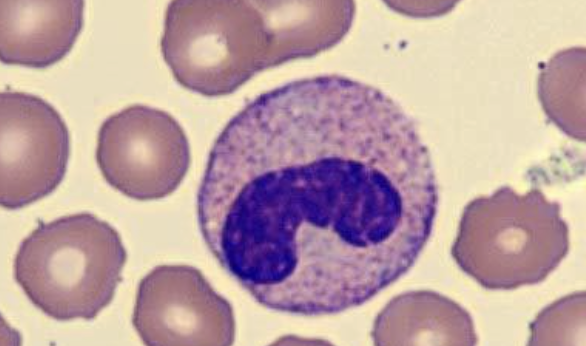
term image
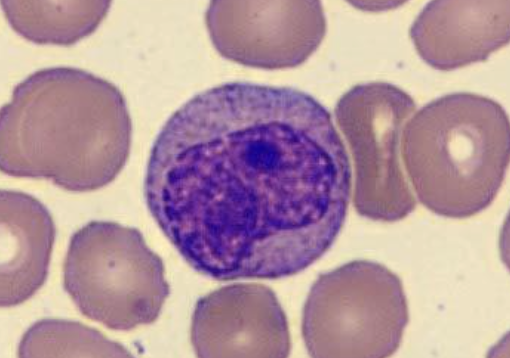
term image
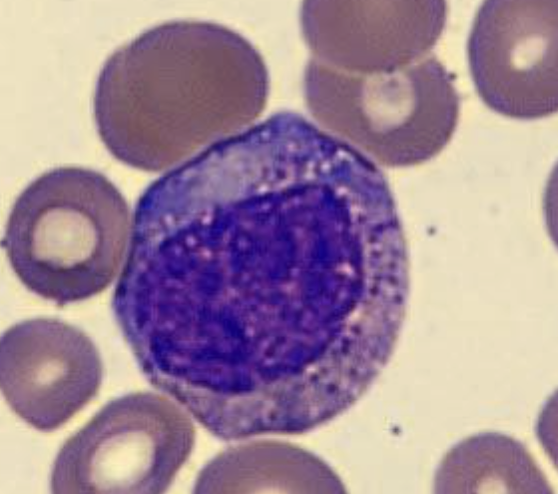
term image
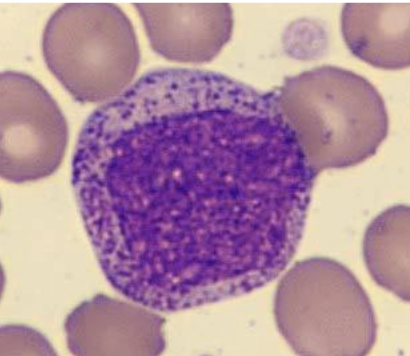
term image
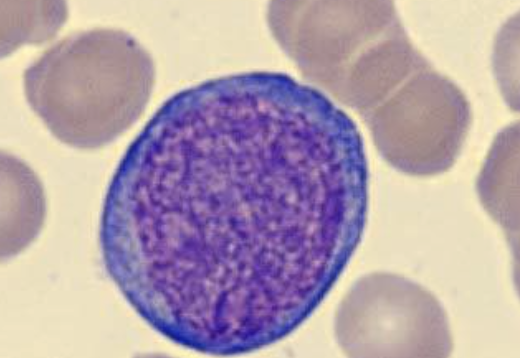
term image
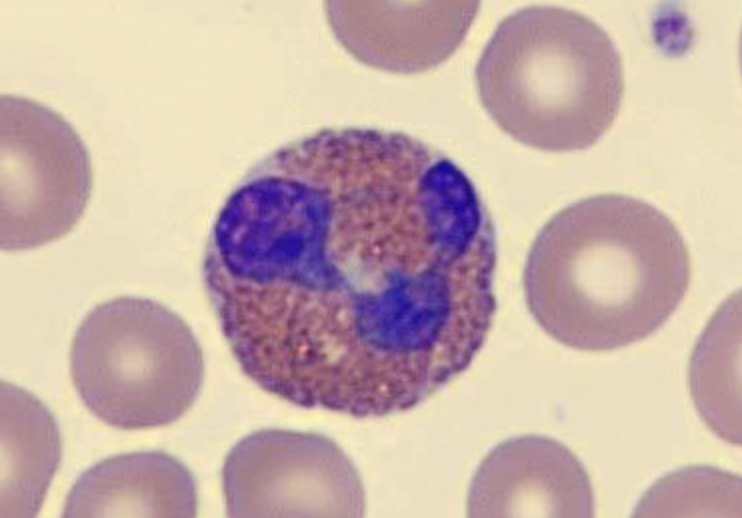
term image
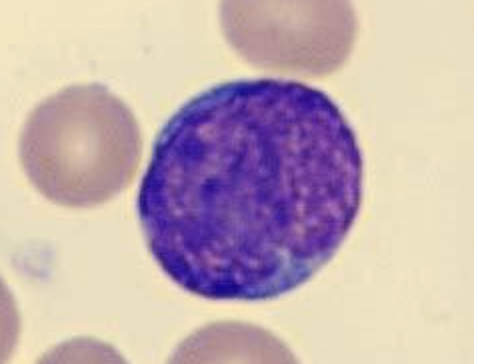
term image
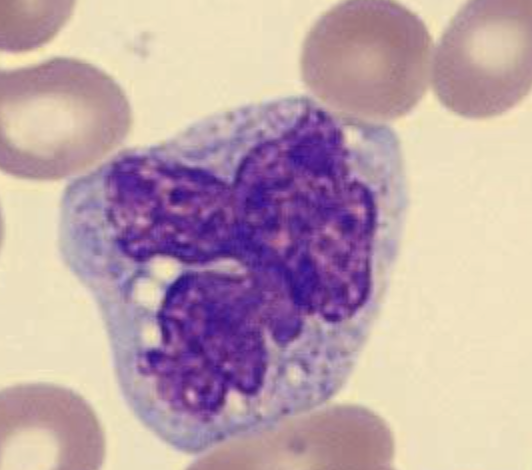
term image
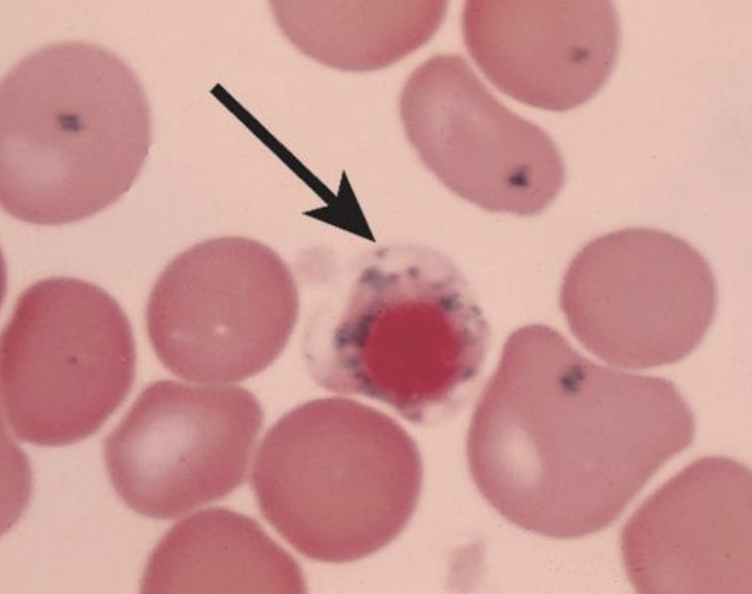
term image
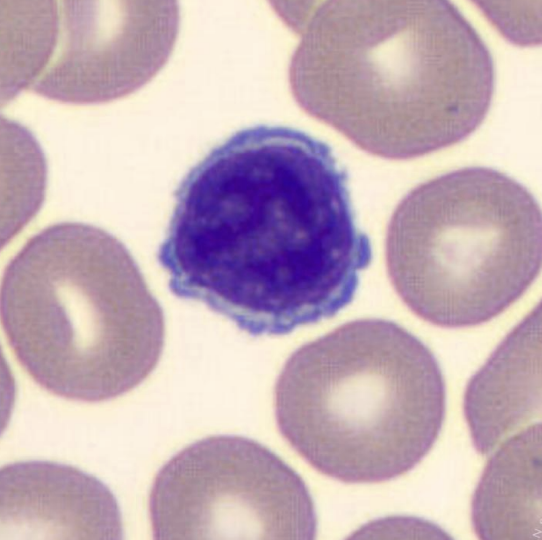
term image
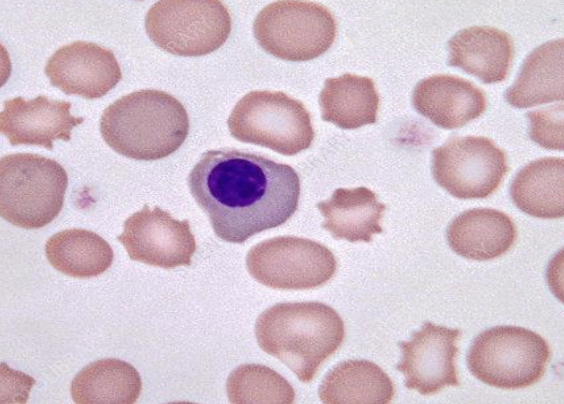
term image
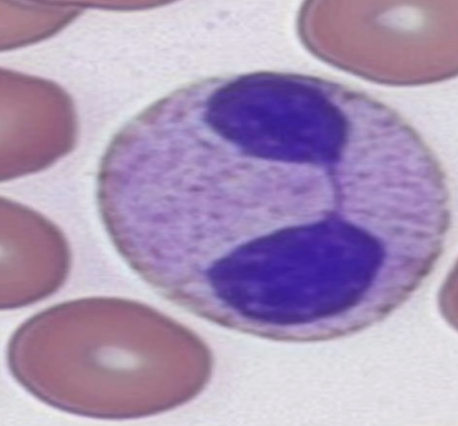
term image
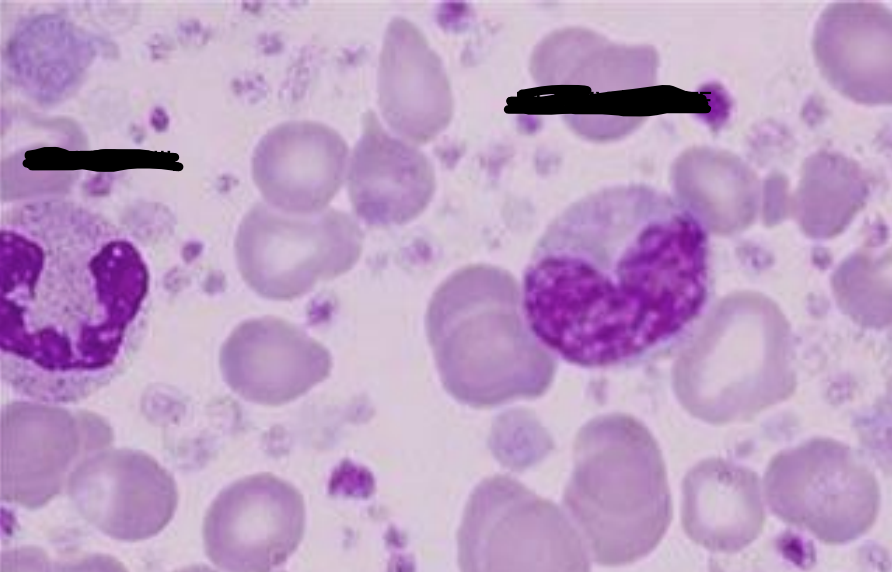
term image
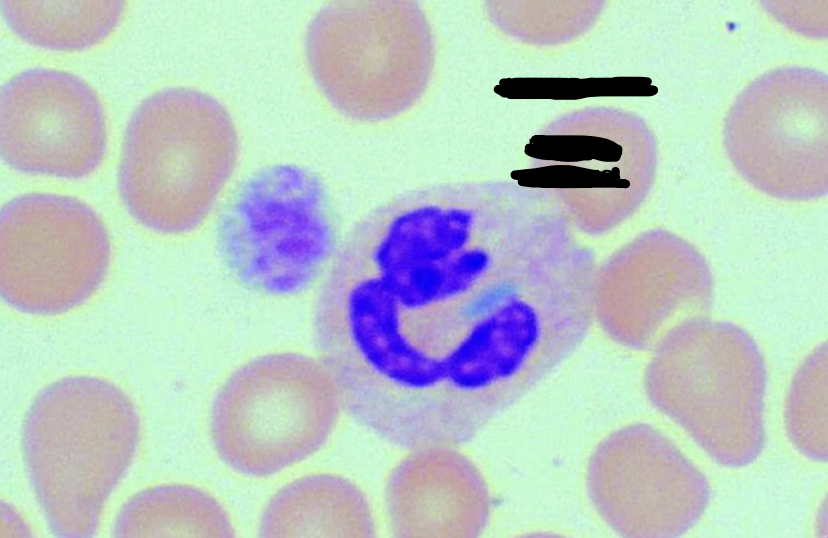
term image
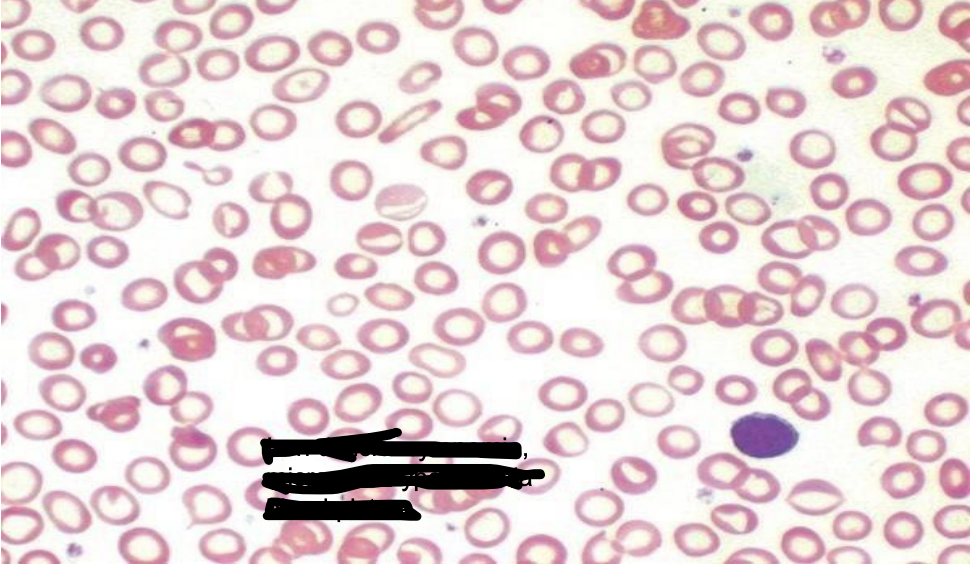
term image
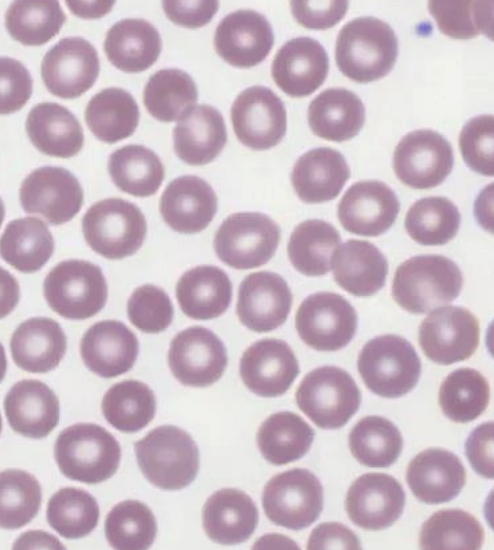
term image
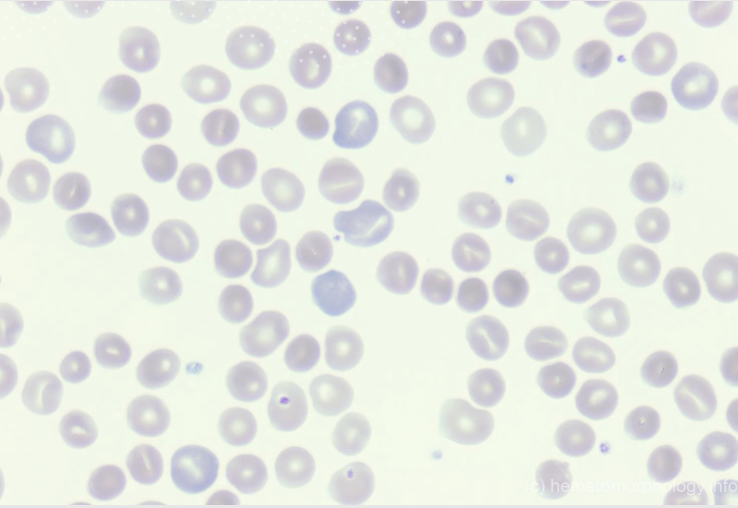
term image
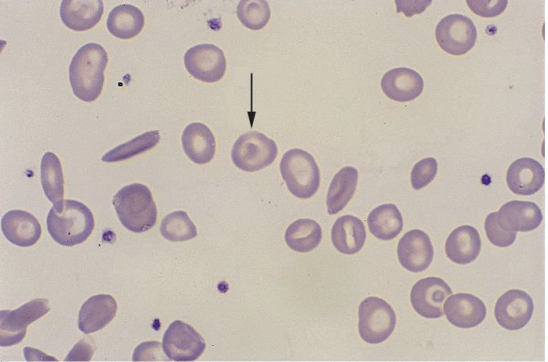
term image
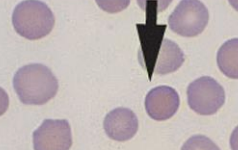
term image
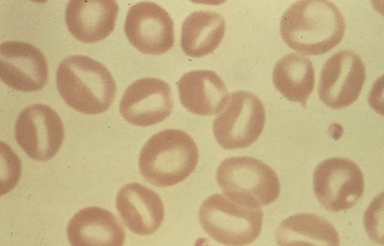
term image
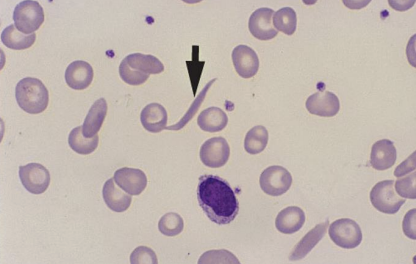
term image
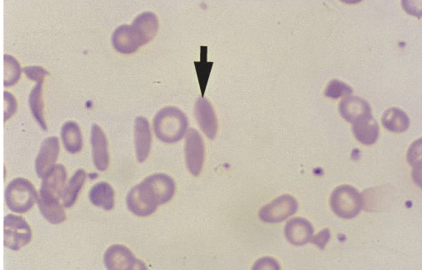
term image
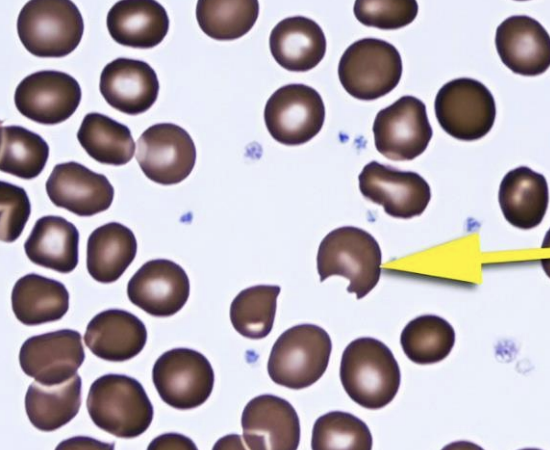
term image
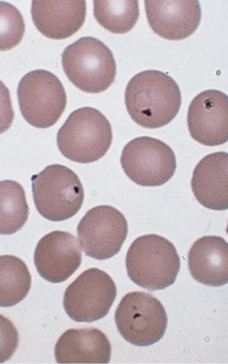
term image

1/54
Looks like no tags are added yet.
Name | Mastery | Learn | Test | Matching | Spaced | Call with Kai |
|---|
No analytics yet
Send a link to your students to track their progress
what iam
Small lymphocyte
what iam
large lymphocyte.
what iam
neutrophils: cytoplasm soft pink, nucleus: deep purple, thin chromatin thread.
metamyelocyte:

burr cells


Acanthocytes (Spur cells / Thorn cells)

dacrocytes or teardrop cells

howell-jolly bodies (RBC inclusions)

Heinz bodies, inclusions comes from denatured (HgB inside the rbc).

Basophilic stippling: RBC with RNA rampant.

pappenheimer bodies: contains iron depositss
Hemoglobin C crystals : abnormal HgB C inside T, seen in hCCC
hemoglobin SC crystals
protozoan inclusions malaria
large platelet
toxic granulation

Dohle body, blue dot RER rampants

toxic vacuolization
hyposegmentation : Pelger-Huët anomaly (a benign genetic mutation)

hypersegmentation: b12 and folic deficiency.
band
metamyelocyte, cytoplasm: pink, Nucleus: kidney, BM: CML, MDS
myelocyte nucleus: round/oval, cytoplasm: Blue
promyelocyte, nucleus: takes up the cytoplasm, cytoplasm deep blue ( (immature)
myeblast: nucleus round, cytoplasm: deep blue, no granules
eosinophil, nucleus: 2 segment, pink granules, cytoplasm: not visible

basophil, nucleus: kidney, cytoplasm: pale blue full of purple granules
lymphoblast, lack granules, nucleoli small circle: 2-3
monocyte, nucleus: weird shape, cytoplasm: pale.

ERYTHROPOIESIS / Erythroblasts (NRBC)
sideroblast

pyknotic neutrophil

platelet clumps (aggregates)

atypical lymph
lymphocyte
nuceated rbc

band eosinophil.

toxic band
bi lobe neutrophil seen in pelger huet anomaly.
neutrophil, metamyelocyte
dohle body
iron deficiency, microcytic, hypochromic.

describe each cells.
normocytes
polychromasia
target cells (codocytes)
spherocytes
stomatocytes
irreversible sickle cells
reversible sickle cells

Burr cell (A) , Acanthocyte (B), Blister cell (C), Schistocyte (D
helmet/bitecells

babesia microti
protozoan inclusions

lymphoma cell